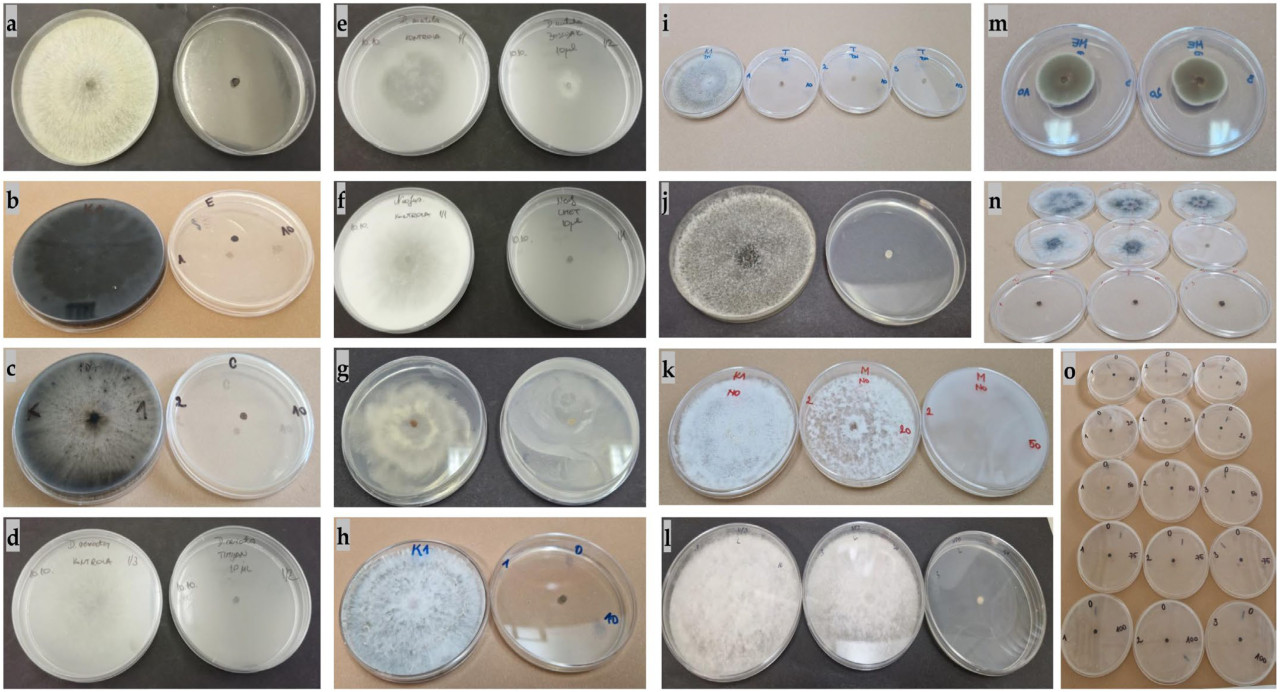
Preview image

Корица и душица: природная альтернатива химикатам в борьбе с болезнями оливы
Противогрибковая активность эфирных масел (EOs) и их основных компонентов была исследована на 14 фитопатогенных грибах, выделенных с оливковых деревьев. В работе использовали коммерческие EOs базилика священного (Ocimum tenuiflorum L.), корицы китайской (Cinnamomum aromaticum Ness), лимона (Citrus × limon), мяты перечной (Mentha × piperita L.), душицы (Origanum compactum Benth) и тимьяна (Thymus vulgaris L.), а также компоненты: эвгенол, Е-коричный альдегид, лимонен, ментол, карвакрол и тимол.
Аннотация
Эффективность оценивали в отношении шести видов грибов семейства Botryosphaeriaceae: Botryosphaeria dothidea (Moug. ex Fr.) Ces. & De Not.; Diplodia mutila (Fr.) Fr.; D. seriata De Not.; Dothiorella iberica A.J.L. Phillips, J. Luque & A. Alves; Do. sarmentorum (Fr.) A.J.L. Phillips, Alves & Luque; и Neofusicoccum parvum (Pennycook & Samuels) Crous, Slippers & A.J.L. Phillips. Другие протестированные виды включали Biscogniauxia mediterranea (De Not.) Kuntze, B. nummularia (Bull.) Kuntze; Cytospora pruinosa Défago; Nigrospora gorlenkoana Novobr.; N. osmanthi Mei Wang & L. Cai; N. philosophiae-doctoris M. Raza, Qian Chen & L. Cai; Phaeoacremonium iranianum L. Mostert, Grafenhan, W. Gams & Crous; и Sordaria fimicola (Roberge ex Desm.) Ces. & De Not.
Результаты показывают, что EOs китайского коричника и душицы, а также их основные компоненты, полностью подавляли рост всех тестируемых грибов, что указывает на их потенциал в качестве агентов биологического контроля в устойчивом сельском хозяйстве. Наименее эффективными оказались обработки EOs лимона и мяты перечной, а также компонентами лимоненом, ментолом и тимолом. Примечательно, что грибы Do. iberica и N. gorlenkoana проявили наибольшую чувствительность ко всем примененным обработкам.
1. Введение
Выращивание оливок, вероятно, началось раньше, чем культивирование любого другого вида деревьев [1]. Традиционно оливковые рощи в Средиземноморье ассоциируются с высоким биоразнообразием, служа примером сельскохозяйственной системы с высокой природной ценностью и важной экологической ролью [1]. Согласно последним данным, в 2022 году мировое производство оливок составило приблизительно 21,4 млн тонн, выращиваемых на площади 10,9 млн га [2]. В Европейском союзе (ЕС) выращивание оливок переходит от традиционных низкоплотностных методов к современным высокоплотностным системам, включая суперинтенсивные плантации. Этот переход направлен на повышение урожайности при одновременном снижении затрат на сбор урожая. Однако эти изменения существенно повлияли на распространенность и тяжесть заболеваний растений [1]. Более того, как указано в нашем предыдущем исследовании [3], растущая заболеваемость растений также напрямую связана с изменением климата [4]. В Средиземноморье, благодаря его уникальному климату и высокому биоразнообразию, сообщается о растущем числе новых патогенных видов. Kim et al. [5] идентифицировали Средиземноморье как один из наиболее уязвимых регионов мира в контексте изменения климата, предполагая, что в будущем количество сообщений о патогенах растений будет продолжать расти. Согласно литературным данным, распространенные причины заболеваний оливы включают виды из семейства Botryosphaeriaceae [6,7], Colletotrichum spp. [8,9], Diatrype spp. [6], Venturia oleaginea (Castagne) Rossman & Crous [10], Verticillium dahliae Klebahn [11] и другие. Кроме того, сообщения о новых патогенах оливы продолжают поступать [3,12,13,14,15,16].
Для защиты оливковых культур от грибковых заболеваний обычно применяются фунгициды. Однако были высказаны опасения относительно их воздействия на окружающую среду, рисков для нецелевых организмов, потенциальной опасности для здоровья человека и влияния на качество продукции [1]. Чрезмерное использование и неконтролируемое применение фунгицидов привело к появлению более вирулентных штаммов, устойчивых к ранее эффективным препаратам [17]. Фунгициды содержат различные вредные вещества, которые могут негативно влиять на здоровье человека и животных, а также на биоразнообразие [18]. ЕС ставит целью снизить зависимость от пестицидов в оливководстве, продвигая агрономические стратегии с низким воздействием на окружающую среду и разрабатывая новые системы управления [1]. В ответ на проблемы, связанные с использованием пестицидов, ЕС принял два ключевых стратегических документа: «Европейское зеленое соглашение», которое включает стратегии по обеспечению устойчивости экономики ЕС, и «Стратегию в области биоразнообразия», направленную на сокращение использования пестицидов на 50% к 2030 году.
В свете вышесказанного растет спрос на альтернативные методы защиты растений, включая использование биологических агентов. В качестве альтернативы химическим средствам защиты растений могут быть использованы различные растительные соединения и экстракты, обладающие противогрибковыми свойствами в отношении различных фитопатогенных грибов [19]. Растения производят фитохимические вещества с антимикробными свойствами, служащие защитными механизмами против вредных микроорганизмов. Эти вещества, известные как ботанические пестициды или ботаникалы, могут быть токсичны для грибковых патогенов при применении на зараженных культурах [20].
Эфирные масла (EOs) стали объектом все большего числа исследований благодаря их доказанной эффективности против конкретных видов грибов. Эти природные соединения, являющиеся вторичными метаболитами растений, обладают сильными антимикробными свойствами и находят применение в различных отраслях промышленности, таких как текстильная, косметическая и пищевая [21,22,23,24]. EOs известны и ценятся с древних времен [25]. Они служат естественной защитой растений от хищников и представляют собой летучие жидкие смеси различных ароматических соединений [26]. Международная организация по стандартизации (ISO) определяет EO как продукт, полученный путем водной или паровой дистилляции, механической обработки или сухой перегонки натуральных материалов [21]. Экстракция EOs из трав восходит к древним персидским и египетским алхимикам, которые кипятили ароматические травы в герметичной колбе, давали им остыть и собирали тонкий слой EO, плавающий на поверхности воды [27]. Современные процессы экстракции достигают схожих результатов с помощью дистилляции, при которой пар пропускается над травами, а не кипячением их непосредственно в воде [27]. Например, цитрусовые EOs, обычно извлекаемые путем дробления кожуры между вальцами в процессе, известном как экспрессия или холодное прессование, также могут быть получены с помощью паровой дистилляции, как в случае с EO лимона, который получают из кожуры и который не содержит витамина С или лимонной кислоты; EO мяты перечной, экстрагируемое из надземных частей, в основном листьев, гибрида Mentha aquatica L. и Mentha spicata L., собирают до цветения, чтобы избежать включения молекул, вызывающих запах; а EO тимьяна получают путем паровой дистилляции листьев растения [27]. EOs отличаются от растительных масел по своей химической структуре, что придает им специфические ароматы. Они легковоспламеняющиеся и быстро испаряются при температурах от 40 до 80 °C [27]. Известно примерно 3000 различных EOs [21].
EOs состоят из гибкой комбинации компонентов, причем процентное содержание варьируется в зависимости от года, партии и других факторов. Например, EOs, полученные из одного и того же ботанического вида, даже клонированные из идентичных растений, дают разный химический состав при выращивании в различных климатических условиях или географических регионах [27]. EOs могут содержать более 60 компонентов, причем два или три основных компонента присутствуют в высоких концентрациях [22]. Основными компонентами EOs часто являются терпены и терпеноиды, реже встречаются компоненты, содержащие азот и серу, кумарины и гомологи фенилпропаноидов [28,29]. Как правило, до трех основных компонентов составляют 90% EO, в то время как остальные присутствуют в количестве менее 1% [30]. Burt [31] отметил, что минорные компоненты играют ключевую роль в антимикробных свойствах EOs, возможно, благодаря их синергетическому взаимодействию с другими компонентами. Химический состав EOs обычно анализируют с помощью газовой хроматографии и сочетания газовой хроматографии с масс-спектрометрией [32].
Ćosić et al. [33] и Karimi et al. [34] сообщили, что ингибирующий потенциал EOs в отношении микроорганизмов зависит от типа EO, химического состава, типа патогена, вида растения-хозяина, применяемых концентраций или объемов, а также агрономических практик. Некоторые гипотезы предполагают, что антимикробная активность EOs обусловлена их липофильностью, свободными гидроксильными группами и ненасыщенными циклическими структурами [22].
Целью данного исследования было изучение противогрибкового потенциала коммерческих EOs и их основных компонентов в отношении 14 видов патогенных грибов, поражающих оливковые деревья, ранее идентифицированных в нашем исследовании, в поисках устойчивой и экологически безопасной альтернативы традиционным химическим фунгицидам. В ходе исследования также оценивались их фунгистатические и фунгицидные свойства, а также определялись их минимальные ингибирующие концентрации (MIC) и минимальные фунгицидные концентрации (MFC).
2. Материалы и методы
2.1. Фитопатогенные грибы
Для оценки воздействия EOs и их основных компонентов были использованы репрезентативные изоляты фитопатогенных грибов, полученные с оливковых деревьев. Список использованных видов представлен в Таблице 1. Изоляты чистых культур инокулировали на картофельно-декстрозный агар (PDA) и инкубировали при 25 °C в течение 7 дней в темноте для видов семейства Botryosphaeriaceae, Biscogniauxia spp., Cytospora sp. и Sordaria sp., и в течение 10 дней для Phaeoacremonium sp. Кроме того, Nigrospora spp. инкубировали при 28 °C в течение 7 дней в темноте.
Таблица 1. Список использованных видов грибов, выделенных с оливок в Хорватии, их названия изолятов и ссылки.
2.2. Эфирные масла и компоненты
Для тестирования противогрибковой активности использовали шесть коммерческих EOs, а также основной компонент каждого EO. EOs были получены из Cinnamomum aromaticum Nees (корица китайская), Citrus × limon (лимон), Mentha × piperita L. (мята перечная), Ocimum tenuiflorum L. (базилик священный), Origanum compactum Benth (душица) и Thymus vulgaris L. (тимьян). Полные названия растений, из которых были получены EOs, их латинские названия и синонимы, а также их основные компоненты, присутствующие в концентрациях более 0,1%, перечислены в Таблице S1, наряду с названиями использованных фунгицидов и их действующими веществами. EOs, за исключением EO C. × limon, были получены от Pranarōm International Ltd. (Ат, Бельгия), в то время как EO C. × limon был получен от Fagron Hrvatska d.o.o. (Донья Зелина, Хорватия). Все EOs были проанализированы с помощью газовой хроматографии-масс-спектрометрии (ГХ-МС) в лаборатории производителя. Компоненты карвакрол, эвгенол и ментол были получены от Thermo Fisher Scientific Inc. (Фэр-Лон, Нью-Джерси, США), Е-коричный альдегид и лимонен — от Thermo Fisher GmbH (Кандель, Германия), а тимол — от VWR International (Левен, Бельгия).
EOs тестировали в пяти концентрациях, а именно 10 мкл/10 мл, 20 мкл/10 мл, 50 мкл/10 мл, 75 мкл/10 мл и 100 мкл/10 мл, что соответствует объемным долям 0,1%, 0,2%, 0,5%, 0,75% и 1,0% в субстрате соответственно. Тестируемая концентрация основного компонента рассчитывалась на основе его процентного содержания в EO для каждой тестируемой концентрации EO [36,37]. Чистый PDA использовали в качестве положительного контроля. В качестве отрицательного контроля использовали два коммерческих фунгицида, обычно применяемых для борьбы с фитопатогенными грибами в оливководстве: Nativo 75WG (Bayer d.o.o., Загреб, Хорватия) и Cabrio TOP (BASF Croatia, Загреб, Хорватия). Фунгициды разводили до рабочей концентрации, рекомендованной для обработки оливковых деревьев согласно инструкции производителя. Концентрация для Nativo 75WG составляла 20 г/100 л, а для Cabrio TOP — 200 г/100 л. Вместо воды использовали такое же количество картофельно-декстрозного агара (PDA) в соответствии с Palfi [37].
2.3. Процедура
EOs и их компоненты использовали для оценки контактного фазового эффекта на рост мицелия грибных изолятов. PDA готовили в соответствии с инструкциями производителя, и температуру всего субстрата контролировали до тех пор, пока он не остывал приблизительно до 50 °C. После охлаждения 10 мл PDA разливали в стерильную пробирку Falcon. Затем в пробирку пипеткой вносили соответствующее количество EO/компонента/фунгицида, смесь перемешивали стеклянной палочкой и осторожно вортексировали до получения гомогенного раствора. Раствор разливали в стерильные чашки Петри диаметром 90 мм. После застывания субстрата пробочным сверлом вырезали блок диаметром 4 мм из активно растущей грибной культуры и инокулировали его в центр субстрата стерильной лабораторной иглой, помещая блок верхней стороной вниз на среду. Чашки Петри запечатывали парафилмом и инкубировали в соответствующих условиях. Всю процедуру выполняли в ламинарном шкафу (Nüve LN 090, Анкара, Турция). Для Botryosphaeriaceae spp., Biscogniauxia spp., Cytospora sp., Phaeoacremonium sp. и Sordaria sp. температура инкубации составляла 25 °C, а для Nigrospora spp. — 28 °C. Эксперимент проводили в трехкратной повторности для каждой обработки (EOs/компоненты/фунгициды) и концентрации. Рост грибного мицелия измеряли через 2, 4 и 10 дней после инокуляции. Диаметр блока мицелия вычитался из отображаемых значений, поэтому максимальный рост для всех видов, кроме P. iranianum, составляет 86 мм, а для P. iranianum — 26,7 мм.
Для изолятов, у которых не наблюдалось роста грибов при окончательном измерении, половина блока мицелия переносилась стерильной лабораторной иглой в новую стерильную чашку Петри, содержащую чистый PDA. Образцы инкубировали в тех же условиях, что и при инокуляции с обработками. Если после инкубации рост гриба возобновлялся, обработка классифицировалась как фунгистатическая, а если роста мицелия не происходило, обработка считалась фунгицидной. Самая низкая концентрация EO или компонента, которая приводила к полному ингибированию роста мицелия, регистрировалась как MIC, а самая низкая концентрация, проявляющая фунгицидную активность, регистрировалась как MFC.
2.4. Статистический анализ данных
Чтобы определить, существуют ли статистически значимые различия в примененных обработках и оценить взаимодействия между всеми группами, сначала был проведен двухфакторный дисперсионный анализ (ANOVA), учитывающий все дни измерения, обработки и концентрации, с использованием Python 3.8.10 (Python Software Foundation, Уилмингтон, Делавэр, США). Впоследствии были проведены однофакторный ANOVA и множественные сравнения с использованием критерия Тьюки в SAS Enterprise Guide 8.4 (SAS Institute, Кэри, Северная Каролина, США) для оценки противогрибковой эффективности обработок. Данные были выражены как средние арифметические значения, стандартные отклонения и 95% доверительные интервалы для среднего. В отдельных случаях, когда результаты однофакторного ANOVA не показывали значительных различий между обработками, но наблюдались визуальные различия, для сравнения конкретных пар были проведены дополнительные Т-тесты с использованием SAS Enterprise Guide 8.4 (SAS Institute, Кэри, Северная Каролина, США). Ингибирующий эффект EOs и компонентов на рост мицелия фитопатогенных грибов рассчитывали в Microsoft Office Excel на основе формулы Wu et al. [38]:
где I (%) — процент ингибирования роста мицелия тестируемыми соединениями, C — диаметр роста гриба на контроле, а T — диаметр роста гриба на обработанном PDA.
3. Результаты
Результаты двухфакторного ANOVA, проведенного для каждого гриба с учетом всех факторов — примененных обработок, дней измерения и концентраций — показали, что комбинация всех трех факторов значительно влияет на рост мицелия. При изучении взаимодействия между обработками (EO/компонент/фунгицид) и концентрацией было обнаружено высокозначимое взаимодействие, указывающее на то, что эффект концентрации на рост мицелия зависит от типа обработок. Аналогично, при анализе взаимодействия между обработками и днями измерения наблюдалось высокозначимое взаимодействие, свидетельствующее о том, что эффекты обработок меняются со временем. Кроме того, при оценке взаимодействия между применяемыми концентрациями и днями измерения было обнаружено значительное взаимодействие, указывающее на то, что эффект концентрации зависит от дня измерения.
Дополнительно, при рассмотрении всех трех факторов — обработок, применяемых концентраций и дней измерения — было выявлено высокозначимое трехфакторное взаимодействие. Это означает, что оптимальная эффективность обработки зависит от конкретной комбинации типа EO/компонента/фунгицида и концентрации, а эффективность отдельных обработок снижается с течением времени.
В следующем разделе представлены результаты статистического анализа, сгруппированные по видам грибов. Результаты однофакторного ANOVA и проценты ингибирования роста мицелия показаны в таблицах в Дополнительном файле (Таблицы S2–S29). Средние значения роста мицелия на 10-й день представлены графически с использованием Microsoft Office Excel. Значение EC50 не могло быть рассчитано из-за отсутствия вариабельности в данных.
3.1. Дотидеомицеты (Dothideomycetes)
3.1.1. Botryosphaeria dothidea
На основании результатов однофакторного ANOVA (Таблица S2), EOs китайской корицы, душицы и тимьяна, а также компоненты карвакрол и Е-коричный альдегид были наиболее эффективными в ингибировании роста мицелия. При концентрации 0,1% они полностью подавляли рост мицелия (Таблица S3). Эти обработки продемонстрировали большую эффективность, чем тестированные коммерческие фунгициды (Рисунок 1). Фунгицид Cabrio TOP подавлял рост на 71,7% после двух дней, на 22,9% после четырех дней и на 9,7% после 10 дней. Для сравнения, Nativo 75WG был более эффективен в подавлении роста мицелия, обеспечивая 100% ингибирование на второй и четвертый дни измерения и 95,7% ингибирование на 10-й день.
Рисунок 1. Средние значения роста мицелия на 10-й день измерения, показанные по концентрациям для всех использованных эфирных масел/компонентов/фунгицидов и контроля для видов Botryosphaeria dothidea, Diplodia mutila, D. seriata, Dothiorella iberica, Do. sarmentorum и Neofusicoccum parvum.
Тимол показал немного более слабый эффект ингибирования роста мицелия по сравнению с вышеупомянутыми EOs и компонентами. При концентрации 0,1% тимол достигал 68,6% ингибирования на второй день; однако к четвертому дню мицелий полностью колонизировал чашку Петри. При концентрации 0,2% мицелий полностью покрывал чашку к 10-му дню. При концентрациях 0,75% и 1,0% роста мицелия не наблюдалось к четвертому дню, но к 10-му дню рост возобновился с показателями ингибирования 54,7% и 60,9% соответственно.
EO базилика священного показало ограниченную эффективность при 0,1%, но при 0,2% оно полностью подавляло рост. При обработке основным компонентом EO базилика, эвгенолом, мицелий демонстрировал более медленный рост по сравнению с контролем при концентрации 0,1%. Однако при 0,2% рост мицелия был полностью подавлен.
EO мяты перечной начало подавлять рост мицелия при концентрации 0,2%. С увеличением концентрации ингибирование также возрастало. Хотя это EO значительно замедляло рост гриба по сравнению с контролем, мицелий все же полностью заполнял чашку Петри к 10-му дню при концентрации 1,0%. EO лимона, а также компоненты ментол и лимонен оказались неэффективными. Даже при концентрации 1,0% эти обработки не оказывали влияния на рост мицелия в течение всего периода измерения.
3.1.2. Diplodia mutila
На основании результатов однофакторного ANOVA (Таблица S4), EOs китайской корицы и душицы, а также компоненты карвакрол, Е-коричный альдегид и эвгенол доказали свою высокую эффективность в ингибировании роста мицелия, превзойдя фунгициды (Рисунок 1). При концентрации 0,1% они подавляли рост мицелия на 100% во все дни измерения, тогда как фунгициды Cabrio TOP и Nativo 75 WG подавляли рост на второй день на 81,2% и 100%, на четвертый день — на 57,8% и 90,3%, а на 10-й день — на 17,1% и 76,7% (Таблица S5).
EO базилика священного и тимьяна показали немного более низкую эффективность. Базилик подавлял рост мицелия на 73,6% на второй день при концентрации 0,1%, но к четвертому дню мицелий заполнил чашку Петри. Тимьян был несколько эффективнее, подавляя рост на 100% на второй день и на 73,3% на четвертый день, но к 10-му дню мицелий заполнил чашку Петри. Оба EO подавляли 100% рост мицелия при концентрации 0,2% во все дни измерения. Компонент тимол показал ингибирующий эффект на рост мицелия при самой низкой концентрации по сравнению с контролем. При самой высокой концентрации он подавлял рост мицелия на 100% на второй и четвертый дни и на 78,7% на 10-й день.
EO мяты перечной и лимона оказали более слабое влияние на ингибирование роста мицелия. Мята перечная проявила эффективность при концентрации 0,1%, в то время как лимон — при концентрации 0,2% и выше. Для обоих EOs ингибирующий эффект снижался со временем, причем наиболее выраженный эффект наблюдался на второй день. С увеличением концентрации процент ингибирования увеличивался, но этот эффект не был длительным и снижался к 10-му дню. Сравнение этих двух EOs показало, что мята перечная была более эффективной, подавляя рост при концентрации 1,0% на 89,5% и 48,8% на второй и четвертый дни соответственно, в то время как к 10-му дню мицелий заполнил чашку Петри. Их основные компоненты, ментол и лимонен, были менее эффективны, чем сами EOs. Ментол подавлял рост только при концентрациях 0,75% и 1,0% на второй день, в то время как лимонен был неэффективен даже при самой высокой концентрации.
3.1.3. Diplodia seriata
На основании результатов однофакторного ANOVA (Таблица S6), EOs китайской корицы, душицы и тимьяна, а также компоненты карвакрол и Е-коричный альдегид доказали свою высокую эффективность в ингибировании роста мицелия, превзойдя фунгициды (Рисунок 1). При концентрации 0,1% они подавляли рост мицелия на 100% во все дни измерения. EO базилика священного и его компонент эвгенол также показали высокую эффективность, подавляя рост мицелия на 100% при концентрации 0,2% (Таблица S7). Cabrio TOP и Nativo 75 WG не полностью подавляли рост мицелия грибов в применяемых концентрациях. Сравнивая эти два фунгицида, Nativo 75WG продемонстрировал большую эффективность, подавляя рост мицелия на 71,7% на 10-й день, в то время как Cabrio TOP достиг ингибирования в 30,6%. Компонент тимол также проявил сильный ингибирующий эффект на рост мицелия с увеличением концентрации. При концентрации 1,0% компонент был эффективнее фунгицида Cabrio TOP, хотя на 10-й день измерения он показал более слабый эффект, чем фунгицид Nativo 75WG при той же концентрации.
EO мяты перечной показало очень слабый эффект на ингибирование роста при концентрации 0,2%, подавляя рост всего на 3,1% на второй день. При самой высокой концентрации роста мицелия не наблюдалось на второй день измерения, но к четвертому дню произошло значительное снижение роста с показателем ингибирования 41,1%, а к 10-му дню мицелий заполнил чашку Петри. Аналогичная картина наблюдалась с EO лимона, которое оказалось наименее эффективным. При концентрации 1,0% ингибирование роста было зарегистрировано только на второй день измерения и составило 26,4%. Компоненты лимонен и ментол не оказывали никакого влияния на ингибирование роста мицелия ни в одной из примененных концентраций.
3.1.4. Dothiorella iberica
На основании результатов однофакторного ANOVA (Таблица S8), EOs китайской корицы, базилика священного, лимона, душицы и тимьяна, а также компоненты карвакрол, Е-коричный альдегид и эвгенол продемонстрировали наиболее высокую эффективность в ингибировании роста мицелия. При концентрации 0,1% они подавляли рост мицелия на 100% (Таблица S9). Оба фунгицида полностью подавляли рост мицелия в применяемых концентрациях. В отличие от EO тимьяна, которое было эффективно при всех концентрациях, его компонент тимол показал немного более слабый эффект на ингибирование роста мицелия. После второго и четвертого дней ингибирование роста мицелия составляло 100% при концентрациях 0,1% и 0,2%. Однако к 10-му дню мицелий полностью колонизировал чашку Петри, в то время как при концентрации 0,5% рост мицелия был полностью подавлен во все дни измерения.
EO мяты перечной продемонстрировало значительное ингибирование роста мицелия, даже при концентрации 0,1%, на второй день. Однако к 10-му дню мицелий полностью заполнил чашку Петри (Рисунок 1). При концентрации 0,2% EO мяты перечной полностью подавляло рост мицелия.
Компоненты ментол и лимонен оказали наименьший ингибирующий эффект на рост мицелия по сравнению с другими обработками. Несмотря на это, при всех концентрациях на второй день они показали ингибирование роста мицелия. Однако к четвертому дню мицелий полностью колонизировал чашку Петри. При сравнении этих двух компонентов ментол оказался немного эффективнее лимонена в концентрациях от 0,1% до 0,75% на основе второго дня измерения, где наблюдался ингибирующий эффект на рост мицелия. Однако при концентрации 1,0% лимонен продемонстрировал незначительно более высокий процент ингибирования, превысив ментол на 1,6%.
3.1.5. Dothiorella sarmentorum
На основании результатов однофакторного ANOVA (Таблица S10), EOs китайской корицы и душицы, а также компоненты карвакрол, Е-коричный альдегид и эвгенол доказали свою высокую эффективность в ингибировании роста мицелия (Рисунок 1). При концентрации 0,1% они подавляли рост мицелия на 100% (Таблица S11). Также оба фунгицида подавляли рост мицелия в применяемых концентрациях. EO базилика священного также показало высокую эффективность по сравнению с контролем, подавляя рост мицелия на 100% при концентрации 0,2% на второй и четвертый день. При более низкой концентрации 0,1% было зафиксировано ингибирование 51,9% на второй день измерения, но к четвертому дню мицелий заполнил чашку Петри.
EO тимьяна в концентрациях 0,1% и 0,2% значительно подавляло рост мицелия на второй и четвертый дни, но к 10-му дню мицелий заполнил чашку Петри. Однако концентрация 0,5% подавляла рост на 100%. Его компонент, тимол, начал проявлять ингибирующие эффекты при концентрации 0,2%, в то время как концентрация 1,0% полностью подавляла рост мицелия во все дни измерения. EO мяты перечной в концентрациях 0,1% и 0,2% подавляло рост мицелия на 100% на второй день, но к четвертому дню мицелий заполнил чашку Петри. Концентрация 0,5% полностью подавляла рост мицелия. Для компонента ментола концентрации в диапазоне от 0,1% до 0,5% не оказали влияния на ингибирование роста мицелия. Более медленный рост был отмечен на второй день по сравнению с контролем, причем концентрации 0,75% и 1,0% показали ингибирование роста на 10,5% и 17,1% соответственно, но к четвертому дню измерения мицелий заполнил чашку Петри в обоих случаях. EO лимона и его компонент лимонен не показали никакого эффекта на ингибирование роста мицелия.
3.1.6. Neofusicoccum parvum
На основании результатов однофакторного ANOVA (Таблица S12), EOs китайской корицы и душицы, наряду с их основными компонентами Е-коричным альдегидом и карвакролом, были наиболее эффективными в ингибировании роста мицелия и превзошли фунгициды (Рисунок 1). При концентрации 0,1% они подавляли рост мицелия на 100% во все дни (Таблица S13). EOs базилика священного, мяты перечной и тимьяна также были высокоэффективными, подавляя рост мицелия на 100% при концентрации 0,2%. Из трех упомянутых EOs базилик священный был наиболее эффективным при более низких концентрациях. Эвгенол полностью подавлял рост при концентрации 0,5%.
Фунгицид Nativo 75WG продемонстрировал высокую эффективность, снижая рост мицелия на 92,2% на 10-й день. Напротив, Cabrio TOP был значительно менее эффективен, снижая рост всего на 56,6% на второй день, на 1,9% на четвертый день, и к 10-му дню мицелий заполнил чашку Петри. Тимол влиял на рост мицелия даже при самой низкой концентрации, а при самой высокой концентрации он также подавлял рост мицелия на 10-й день на 40,7%. Лимон, лимонен и ментол не оказали никакого эффекта на ингибирование роста мицелия гриба.
3.2. Сордариомицеты (Sordariomycetes)
3.2.1. Biscogniauxia mediterranea
На основании результатов однофакторного ANOVA (Таблица S14), EOs базилика священного, китайской корицы, душицы и тимьяна, наряду с компонентами карвакролом, Е-коричным альдегидом и эвгенолом, показали себя наиболее эффективными в ингибировании роста мицелия (Рисунок 2), при этом минимальная концентрация 0,1% подавляла рост на 100% во все дни (Таблица S15). Мята перечная и тимол подавляли рост мицелия на 100% при концентрации 0,5%. При более низких концентрациях мята перечная была более эффективной, подавляя рост мицелия на 18,6% и 54,3% на четвертый день при концентрациях 0,1% и 0,2% соответственно. Фунгицид Nativo 75 WG был более эффективным по сравнению с Cabrio TOP, достигая ингибирования 86,8% на 10-й день, в то время как Cabrio TOP показал ингибирование 75,9%.
Рисунок 2. Средние значения роста мицелия на 10-й день измерения, показанные по концентрациям всех использованных эфирных масел/компонентов/фунгицидов и контроля для видов Biscogniauxia mediterranea, B. nummularia, Cytospora pruinosa, Nigrospora gorlenkoana, N. osmanthi, N. philosophiae-doctoris, Phaeoacremonium iranianum и Sordaria fimicola.
EO лимона и компоненты лимонен и ментол оказали влияние на ингибирование роста мицелия при самой низкой концентрации, но только на второй день измерения. При самой высокой концентрации ингибирование также наблюдалось только на второй день. Среди этих обработок EO лимона было наиболее эффективным, с процентом ингибирования 77,3% на второй день измерения. Лимонен был наименее эффективной обработкой, с процентом ингибирования 29,9% на второй день при самой высокой концентрации.
3.2.2. Biscogniauxia nummularia
На основании результатов однофакторного ANOVA (Таблица S16), EOs базилика священного, китайской корицы, душицы и тимьяна, а также компоненты карвакрол, Е-коричный альдегид и эвгенол, наряду с фунгицидом Nativo 75WG, были признаны наиболее эффективными в ингибировании роста мицелия. При минимальной концентрации 0,1% EOs и компоненты подавляли рост мицелия на 100% во все дни измерения (Таблица S17). Мята перечная подавляла рост мицелия на 100% при концентрации 0,5%. При более низких концентрациях она также оказывала влияние на ингибирование роста мицелия. Однако при минимальной концентрации процент ингибирования составил всего 2,7% на второй день и 28,7% на четвертый день, а к 10-му дню мицелий заполнил чашку Петри. Фунгицид Cabrio TOP показал немного более низкую эффективность по сравнению с Nativo 75WG, но все же был значимым по сравнению с контролем во все дни, подавляя рост на 100% на второй день, на 97,3% на четвертый день и на 92,2% на 10-й день.
EO лимона и компоненты лимонен и ментол показали заметные эффекты в ингибировании роста мицелия при самой низкой концентрации на второй и четвертый дни. Однако даже при самой высокой концентрации мицелий полностью заполнял чашку Петри к 10-му дню во всех трех обработках (Рисунок 2). Среди этих обработок ментол был наименее эффективным при самой высокой применяемой концентрации, подавляя рост мицелия на 50% на четвертый день, в то время как лимонен был наиболее эффективным, подавляя рост на 90,3% в тот же день.
3.2.3. Cytospora pruinosa
На основании результатов однофакторного ANOVA (Таблица S18), EOs китайской корицы и душицы, а также компоненты карвакрол, Е-коричный альдегид, эвгенол и тимол были высокоэффективны в ингибировании роста мицелия. При минимальной концентрации 0,1% они подавляли рост мицелия на 100% во все дни. Оба фунгицида также подавляли рост мицелия в применяемой концентрации. EO мяты перечной подавляло рост мицелия на 100% при концентрации 0,5%, EO тимьяна — при 0,75%, а EO лимона — при 1,0% (Таблица S19). Все три обработки оказывали влияние на ингибирование роста мицелия при более низких концентрациях.
EO базилика священного и компонент ментол не показали роста мицелия ни при какой концентрации после двух и четырех дней, но рост наблюдался на 10-й день. Между этими двумя обработками ментол был более эффективен с ингибированием 95,3% при концентрации 1,0% на 10-й день. Наименее эффективным компонентом для ингибирования роста мицелия был лимонен (Рисунок 2). Процент ингибирования при концентрации 1,0% на 10-й день измерения составил 28,3%.
3.2.4. Nigrospora gorlenkoana
На основании результатов однофакторного ANOVA (Таблица S20), EOs китайской корицы, базилика священного, душицы, мяты перечной и тимьяна, а также компоненты карвакрол, Е-коричный альдегид и эвгенол доказали свою высокую эффективность в ингибировании роста мицелия. При минимальной концентрации 0,1% EOs и компоненты подавляли рост мицелия на 100% во все дни измерения. Кроме того, оба фунгицида подавляли рост мицелия на 100% в применяемых концентрациях. Компонент тимол подавлял рост мицелия на 100% при концентрации 0,5% (Таблица S21), но он также был эффективен при более низких концентрациях, подавляя рост на 24,0% при концентрации 0,1% на второй день, а при концентрации 0,2% подавлял рост на 89,5% и 64,7% на второй и четвертый дни соответственно.
Среди протестированных EOs только лимон проявил слабый эффект в ингибировании роста мицелия (Рисунок 2). Даже при минимальной концентрации наблюдалось ингибирование, но к четвертому дню измерения мицелий полностью заполнял чашку Петри при всех концентрациях. При концентрации 1,0% процент ингибирования на второй день был высоким и составил 86,4%. Компонент лимонен показал эффект ингибирования при концентрации 0,5% только на второй день. При более низких концентрациях он не оказывал влияния на ингибирование роста мицелия. При самой высокой концентрации процент ингибирования на второй день измерения также был высоким и составил 84,5%. Компонент ментол, как и лимонен, подавлял рост при более высоких концентрациях, в данном случае от 0,75% и выше, с ингибированием при самой высокой концентрации 56,6% на второй день.
3.2.5. Nigrospora osmanthi
На основании результатов однофакторного ANOVA (Таблица S22), EOs базилика священного, китайской корицы, душицы и тимьяна, наряду с компонентами Е-коричным альдегидом и карвакролом, были признаны наиболее эффективными в ингибировании роста мицелия. При минимальной концентрации 0,1% они подавляли рост мицелия на 100% во все дни измерения (Таблица S23). Фунгицид Cabrio TOP также подавлял рост мицелия в применяемой концентрации (Рисунок 2). EO мяты перечной подавляло рост мицелия на 100% при концентрации 0,5%. При более низких концентрациях оно также оказывало видимое влияние на рост мицелия. Фунгицид Nativo 75WG также показал эффект на ингибирование мицелия с 100% ингибированием на второй день, 79,1% на четвертый день и 60,1% на 10-й день. EO лимона, даже при самой высокой концентрации, не полностью подавляло рост мицелия, хотя увеличение концентрации приводило к заметному росту ингибирования, аналогично компоненту лимонену. При концентрации 1,0% EO лимона подавляло рост на 80,5% на второй день и на 57,8% на четвертый день, в то время как лимонен показал ингибирование 77,4% и 57,8% в те же дни.
Эвгенол оказал особенно сильное влияние на ингибирование роста мицелия, при этом наблюдались стабильные значения во всех концентрациях. Из-за схожести результатов был проведен двухфакторный ANOVA, который подтвердил, что различные концентрации эвгенола не оказывали статистически значимого влияния на результаты ингибирования, и не было значимого взаимодействия между концентрацией эвгенола и днями измерения. Ментол показал схожие результаты, где изменения концентрации не оказали значительного влияния на результаты ингибирования. Его влияние было заметно только на второй день.
Компонент тимол проявил очень сильный ингибирующий эффект на рост мицелия при более высоких концентрациях, особенно при концентрации 0,5%, хотя к 10-му дню рост мицелия полностью заполнил чашку Петри (Рисунок 2).
3.2.6. Nigrospora philosophiae-doctoris
На основании результатов однофакторного ANOVA (Таблица S24), EOs китайской корицы, базилика священного, душицы и тимьяна, а также компоненты карвакрол, Е-коричный альдегид и эвгенол показали себя наиболее эффективными в ингибировании роста мицелия. При минимальной концентрации 0,1% они подавляли рост мицелия на 100% в течение всех дней измерения (Таблица S25). Фунгицид Cabrio TOP также полностью подавлял рост мицелия (Рисунок 2). Мята перечная, лимон и тимол подавляли рост мицелия на 100% при концентрации 0,5%. Из этих трех обработок при более низких концентрациях тимол был наиболее эффективным. Фунгицид Nativo 75WG показал значительное ингибирование роста мицелия на второй день, но к четвертому дню процент ингибирования составил всего 2,6%, а к 10-му дню мицелий полностью заполнил чашку Петри.
Лимонен и ментол проявили схожие эффекты на ингибирование роста мицелия. Ингибирование роста отмечалось на второй и четвертый дни, хотя к 10-му дню мицелий полностью заполнил чашку Петри. Ингибирование было схожим во всех тестированных концентрациях, хотя наблюдалось небольшое увеличение ингибирования с более высокими концентрациями этих двух компонентов. Лимонен показал немного лучшие результаты, подавляя рост на 18,2% и 12,2% на второй и четвертый дни при концентрации 1,0%, в то время как ментол показал показатели ингибирования 14,1% и 7,9% соответственно.
3.2.7. Phaeoacremonium iranianum
На основании результатов однофакторного ANOVA (Таблица S26), EOs китайской корицы, базилика священного, душицы и тимьяна, наряду с компонентами карвакролом, Е-коричным альдегидом и эвгенолом, а также фунгицидом Cabrio TOP, показали себя наиболее эффективными в ингибировании роста мицелия. При минимальной концентрации 0,1% EOs и компоненты подавляли рост мицелия на 100% во все дни измерения, в то время как EO мяты перечной подавляло рост на 100% при концентрации 1,0% (Таблица S27). Nativo 75WG был менее эффективен по сравнению с фунгицидом Cabrio TOP (Рисунок 2), с процентами ингибирования 22,2% на второй день, 61,9% на четвертый день и 70% на 10-й день.
EO лимона показало самую слабую эффективность среди протестированных EOs. На второй день роста не происходило, но к 10-му дню процент ингибирования при самой высокой концентрации составил 67,5%.
Лимонен, тимол и ментол были компонентами, которые даже при самых высоких концентрациях не полностью подавляли рост мицелия. Лимонен замедлял рост мицелия, и на второй день роста не было, но к четвертому дню рост возобновлялся даже при самой высокой концентрации. Хотя лимонен был более эффективен на начальных стадиях роста по сравнению с тимолом, к последнему дню измерения он оказал более слабое действие, чем тимол. Среди трех компонентов ментол был наименее эффективным, подавляя рост всего на 36,3% на 10-й день при самой высокой концентрации.
3.2.8. Sordaria fimicola
На основании результатов однофакторного ANOVA (Таблица S28), EOs китайской корицы, базилика священного, душицы и тимьяна, наряду с компонентами карвакролом, Е-коричным альдегидом и эвгенолом, а также оба фунгицида, были наиболее эффективны в ингибировании роста мицелия. При минимальной концентрации 0,1% EOs и компоненты подавляли рост мицелия на 100% во все дни измерения. Кроме того, оба фунгицида были эффективны на 100% в применяемых концентрациях. Мята перечная и тимол подавляли рост мицелия на 100% при концентрации ≥0,5% (Таблица S29 и Рисунок 2). Сравнивая эти две обработки, тимол был более эффективен при более низких концентрациях.
Лимон, лимонен и ментол, как и в некоторых предыдущих случаях, показали самую низкую эффективность в подавлении роста фитопатогенных грибов. Среди них лимон был наиболее эффективен, с процентом ингибирования 85,5% на второй день измерения при концентрации 1,0%. Для всех трех обработок ингибирование роста наблюдалось только на второй день.
3.3. Определенные значения MIC и MFC
На основе определенных в этом исследовании значений MIC и MFC было установлено, что EOs китайской корицы и душицы дали наилучшие результаты среди протестированных EOs (Рисунок 3), со значениями MFC 0,1% для всех видов грибов (Таблица S30). EO базилика священного также продемонстрировало высокую эффективность со значениями MFC в диапазоне от 0,1% до 0,2% в зависимости от вида гриба, за исключением Do. sarmentorum, для которого оно составило 0,5%. Для C. pruinosa значение MFC не определено. EO тимьяна показало диапазон MFC от 0,1% до 0,75%. MFC для EO тимьяна не было установлено для B. nummularia, но значение MIC было определено как 0,1%. Для EO лимона значение MIC составило 0,1% для восьми из 14 видов. Обработка не оказала эффекта на B. dothidea, N. parvum или Do. sarmentorum. Значение MFC было определено только для Do. iberica (0,1%), C. pruinosa (1,0%) и N. philosophiae-doctoris (0,5%). Значения MIC для EO мяты перечной варьировались от 0,1% до 0,2% в зависимости от вида гриба. Самое низкое значение MFC было обнаружено для N. gorlenkoana (0,1%), а самое высокое — для P. iranianum (1,0%), в то время как значение MFC не было установлено для B. dothidea, D. mutila или D. seriata.
Рисунок 3. Тестирование противогрибкового потенциала эфирных масел (EOs) на изолятах фитопатогенных грибов с оливковых деревьев: (a) Botryosphaeria dothidea — контроль слева, EO базилика священного в концентрации 0,2% справа, день 10; (b) Dothiorella iberica — контроль слева, компонент эвгенол в концентрации 0,1% справа, день 10; (c) Do. sarmentorum — контроль слева, EO китайской корицы в концентрации 0,1% справа, день 10; (d) Diplodia seriata — контроль слева, EO тимьяна в концентрации 0,1% справа, день 10; (e) D. mutila — контроль слева, EO базилика священного в концентрации 0,1% справа, день 2; (f) Neofusicoccum parvum — контроль слева, EO китайской корицы в концентрации 0,1% справа, день 10; (g) Cytospora pruinosa — обработка EO лимона: концентрация 0,1% слева и 1,0% справа, день 10; (h) Biscogniauxia mediterranea — контроль слева, EO душицы в концентрации 0,1% справа, измерено на день 10; (i) B. nummularia — один контроль крайний слева, с тремя повторностями обработки EO тимьяна в концентрации 0,1% справа, день 10; (j) Nigrospora gorlenkoana — контроль слева, обработка компонентом тимолом в концентрации 0,5% справа, день 10; (k) N. osmanthi — контроль слева, обработка EO мяты перечной в концентрации 0,2% в центре и 0,5% справа, с запотевшей чашкой Петри от паров EO, день 10; (l) N. philosophiae-doctoris — обработка EO лимона: концентрация 0,1% слева, 0,2% в центре и 0,5% справа, день 10; (m) Phaeoacremonium iranianum — обработка компонентом ментолом: концентрация 0,1% слева и 0,2% справа, день 10; (n) Sordaria fimicola — три повторности обработки компонентом тимолом: верхняя концентрация 0,1%, средняя концентрация 0,2% и нижняя концентрация 0,5%, день 10; (o) Botryosphaeria dothidea — обработка EO душицы, с тремя повторностями для каждой концентрации, на день 10, сверху вниз: 0,1%, 0,2%, 0,5%, 0,75% и 1,0%.
Что касается компонентов EOs, наилучшие результаты на основе значений MFC были достигнуты карвакролом и Е-коричным альдегидом. Для компонента эвгенола значение MFC составляло 0,1% для большинства видов, за исключением B. dothidea и D. seriata, где оно составило 0,2%, и N. parvum, где оно составило 0,5%. Для B. nummularia и N. osmanthi значение MFC не определено, но значение MIC составляло 0,1% для обоих видов. Значение MFC для компонента лимонена не было установлено ни для одного вида, а значение MIC не было определено для B. dothidea, D. mutila, D. seriata, Do. sarmentorum и N. parvum. Для других видов значение MIC составляло 0,1%, за исключением N. gorlenkoana, где оно составило 0,5%. Аналогично, значение MFC не было определено для компонента ментола ни для одного вида. Ментол был неэффективен против B. dothidea, D. seriata и N. parvum, в то время как значение MIC составляло 0,75% для D. mutila, Do. sarmentorum и N. gorlenkoana, и 0,1% для остальных видов. Эти результаты свидетельствуют о том, что лимонен и ментол проявили самую слабую противогрибковую активность в отношении фитопатогенных грибов. Для компонента тимола значение MIC составляло 0,1% для большинства грибов, за исключением Do. sarmentorum, где оно составило 0,2%. Значения MFC находились в диапазоне от 0,1% до 0,5% и не были определены для B. dothidea, D. mutila, D. seriata, Do. sarmentorum, N. parvum, N. osmanthi и P. iranianum.
4. Обсуждение
Расширенное культивирование оливковых деревьев значительно повысило спрос на использование средств защиты растений. Кроме того, развитие устойчивости у фитопатогенных грибов представляет собой существенную проблему для производителей [18]. В настоящее время борьба с болезнями оливковых деревьев в значительной степени зависит от применения химических пестицидов, обычно применяемых в соответствии с заранее определенными графиками, а не на основе мониторинга или прогностических систем. Однако растущая осведомленность общественности о загрязнении окружающей среды в этой важной средиземноморской агроэкосистеме, проблемы, возникающие из-за побочных эффектов этих химикатов, и политика ЕС привели к сокращению числа одобренных действующих веществ для борьбы с болезнями оливы. Следовательно, все большее внимание уделяется устойчивому использованию пестицидов и внедрению нехимических альтернатив или стратегий интегрированной защиты растений (IPM) [1].
В последнее время природные соединения исследуются на предмет включения в программы борьбы с болезнями из-за их более быстрых темпов разложения и различных экотоксикологических профилей [1]. Учитывая, что это исследование включало определенные патогены, присутствие которых на оливковых деревьях было обнаружено лишь недавно, существует ограниченное количество исследований по борьбе с ними, особенно на оливках.
Виды из семейства Botryosphaeriaceae являются одними из наиболее агрессивных патогенов оливковых деревьев, причем на сегодняшний день на оливках идентифицировано 22 вида [7]. B. dothidea идентифицирован как возбудитель болезней оливы в Калифорнии [6], Хорватии [7], Греции [39], Италии [40], Черногории [41], Испании [42], Тунисе [43], Турции [44] и Уругвае [45]. D. mutila обнаружен на оливковых деревьях в Калифорнии [6], Хорватии [7], Италии [40] и Уругвае [45]. D. seriata обнаружен на оливковых деревьях в Калифорнии [6], Хорватии [7], Италии [40], Испании [46] и Уругвае [45]. Do. iberica обнаружен на оливковых деревьях в Калифорнии [6] и Хорватии [7]. Do. sarmentorum обнаружен на оливковых деревьях в Хорватии [7] и Италии [47], а N. parvum обнаружен на оливковых деревьях в Хорватии [7], Италии [48], Южной Африке [49] и Уругвае [45].
Ammad et al. [50] провели тесты in vitro по противогрибковой эффективности EO лимона (C. limon) против трех патогенных видов, включая B. dothidea. EO лимона подавляло рост B. dothidea при концентрации 0,25%. Все протестированные концентрации были признаны летальными в условиях теста. В нашем исследовании EO лимона и компонент лимонен (который также был основным компонентом их EO) не подавляли рост мицелия B. dothidea даже при концентрации 1,0%. Li et al. [51] изучали противогрибковый эффект 33 компонентов EOs на B. dothidea, выделенный из киви, включая карвакрол, коричный альдегид, эвгенол, лимонен и тимол. Компоненты карвакрол и тимол оказали наиболее высокий противогрибковый эффект на рост мицелия. В нашем исследовании наиболее эффективными компонентами были карвакрол и Е-коричный альдегид. Zhang et al. [52] тестировали противогрибковую активность 20 чистых соединений против B. dothidea в концентрации 400 мкг/мл, где ментол подавлял рост примерно на 40,2%. В нашем исследовании ментол не оказал влияния на рост мицелия даже при самой высокой концентрации. Wang et al. [53] изучали противогрибковый эффект EOs корицы и гвоздики на B. dothidea, при этом EO корицы проявило более сильный ингибирующий эффект по сравнению с EO гвоздики. Наиболее распространенными компонентами в их EO корицы были транс-коричный альдегид и бензальдегид, тогда как в нашем исследовании это были Е-коричный альдегид и транс-о-метокси-коричный альдегид.
Dai et al. [54] протестировали 17 фунгицидов на их активность in vitro против B. dothidea. Дифеноконазол, тебуконазол и прохлораз были наиболее эффективны в ингибировании роста мицелия, в то время как трифлоксистробин обладал наиболее значительной ингибирующей активностью в отношении прорастания спор. Fan et al. [55] обнаружили, что уровень устойчивости B. dothidea к тебуконазолу со временем значительно повышается. В исследовании Latorre et al. [56] при первоначальном скрининге защитных соединений против N. parvum на стеблях голубики 0,5% тебуконазола была наиболее эффективной обработкой фунгицидом. Twizeyimana et al. [57] изучали действие 12 фунгицидов на грибы семейства Botryosphaeriaceae, включая N. parvum и Do. iberica. На основе их результатов скрининга фунгицидов in vitro пять обработок фунгицидами были наиболее эффективными, включая азоксистробин, флудиоксонил, метконазол, пропиконазол и пираклостробин. В нашем исследовании фунгицид Nativo 75WG (трифлоксистробин + тебуконазол) был более эффективен для всех видов семейства Botryosphaeriaceae по сравнению с Cabrio TOP, за исключением Do. iberica и Do. sarmentorum, где оба фунгицида были эффективны на 100%.
До сих пор не проводилось исследований влияния EOs на Do. iberica и Do. sarmentorum. В нашем исследовании EOs китайской корицы и душицы, а также компоненты Е-коричный альдегид, эвгенол и карвакрол полностью подавляли рост при самой низкой концентрации, в то время как для Do. iberica были эффективны EOs базилика, лимона и тимьяна.
Нет доступных исследований о влиянии EOs на D. seriata и D. mutila. Однако Štůsková et al. [58] изучали влияние фенольных компонентов на рост патогенов виноградной лозы, включая D. seriata и N. parvum. Эвгенол и тимол оказали ингибирующее действие на рост мицелия гриба, причем эвгенол показал лучший эффект в обоих случаях, достигая 100% ингибирования роста при концентрации 2,5 мкл/мл. В нашем исследовании для D. mutila наиболее эффективными EOs при самой низкой концентрации были китайской корицы и душицы, а также компоненты Е-коричный альдегид, эвгенол и карвакрол, в то время как для D. seriata наиболее эффективными были китайской корицы, душицы, тимьяна, а также компоненты Е-коричный альдегид и карвакрол. Sarkhosh et al. [19] тестировали восемь различных EOs против роста фитопатогенных грибов, включая вид Botryosphaeria sp. При 250 мкл/л EO тимьяна и чабера полностью подавляли рост мицелия этого гриба. При норме внесения 1500 мкл/л EO мяты перечной полностью подавляло рост мицелия Botryosphaeria sp. Ни одно из других EOs не подавляло полностью рост мицелия Botryosphaeria sp. ни в одной из протестированных концентраций. Основными компонентами их EO мяты перечной были ментол, ментон и 1,8-цинеол, как и в EO, использованном в нашем исследовании. Некоторые другие компоненты EOs также обладают ингибирующим эффектом на рост грибов, такие как монотерпены [52], лимонен, тимол и 31 другой компонент эфирных масел [51]. Согласно литературным данным, наиболее распространенными компонентами EO китайской корицы являются бензальдегид, фенилпропиловый альдегид, Е-коричный альдегид, 2-метокси-коричный альдегид и (E)-коричный ацетат, которые составляют 90% EO [59,60]. В нашем исследовании, как мы уже упоминали, это были Е-коричный альдегид, транс-о-метокси-коричный альдегид и коричный ацетат. Основными компонентами EO лимона являются лимонен, нераль и транс-вербенол [61]. В нашем исследовании это были лимонен, β-пинен и γ-терпинен. Основными компонентами EO мяты перечной являются ментол, ментилацетат, ментон, ментофуран, β-фелландрен и изоментон [62,63], как и в EO, использованном в нашем исследовании, это были ментол, ментон и 1,8-цинеол. Основными компонентами EO базилика являются эвгенол, (E)-кариофиллен и β-элемен, которые составляют около 98% EO [64]. В нашем исследовании это были эвгенол, β-кариофиллен и эстрагол. Основными компонентами EO тимьяна являются тимол, p-цимол, карвакрол, α-пинен, дуренол и камфора [62,65]. В нашем исследовании это были тимол, p-цимол и γ-терпинен. Основными компонентами EO душицы (O. compactum) являются карвакрол (2,18–63,65%), p-цимол (6,69–42,64%), тимол (0,16–34,29%) и γ-терпинен [66,67]. В нашем исследовании это были карвакрол, γ-терпинен и тимол.
B. mediterranea был зарегистрирован как патоген как в Хорватии, так и в Тунисе [3,12], в то время как B. nummularia был идентифицирован как патоген на оливковых деревьях в Хорватии [3]. В настоящее время нет доступных данных о мерах борьбы с B. nummularia, тогда как в исследованиях по B. mediterranea изучалось использование антагонистических микроорганизмов, таких как Trichoderma spp., Paecilomyces variotii (syn. Bainier Byssochlamys spectabilis (Udagawa & Shoji Suzuki) Houbraken & Samson) и др. [68,69,70,71], а также фунгицидов, включая карбендазим, хлорокись меди 35% WP, манкоцеб и пропиконазол, наряду с лесоводческими методами. Yangui et al. [72] тестировали EOs пяти видов эвкалипта и пять EOs, полученных из Myrtus communis L. из пяти разных мест в Тунисе. Наиболее эффективными были EOs E. camaldulensis Dehnh. и Myrtus sp., собранные в Загуане, которые полностью подавляли рост гриба при концентрации 45 мг/мл. Основываясь на наших результатах, EOs базилика священного, китайской корицы, душицы и тимьяна, а также компоненты Е-коричный альдегид, эвгенол и карвакрол полностью подавляли рост мицелия обоих грибов при концентрации 0,1%.
C. pruinosa был идентифицирован как патоген в Хорватии, Южной Африке и Испании [16,42,73]. На сегодняшний день не проводилось исследований по борьбе с этим патогеном на каких-либо видах растений. В нашем исследовании EOs китайской корицы и душицы, а также компоненты Е-коричный альдегид, эвгенол, карвакрол и тимол, и оба тестированных фунгицида были признаны наиболее эффективными в ингибировании роста мицелия этого патогена.
N. gorlenkoana, N. osmanthi и N. philosophiae-doctoris являются недавно описанными патогенами на оливковых деревьях в мире [35], хотя некоторые виды Nigrospora известны как возбудители пятнистости листьев на различных культурах, таких как фикус лировидный, чай яванский, сахарный тростник и другие [74,75,76]. Нет доступных данных о мерах борьбы конкретно для этих трех патогенов, хотя исследования фунгицидов и других противогрибковых веществ проводились для других видов Nigrospora [77,78]. Мы определили, что EOs базилика священного, китайской корицы, душицы и тимьяна, а также компоненты Е-коричный альдегид и карвакрол, наряду с фунгицидом Cabrio TOP, были наиболее эффективными против всех трех видов. Кроме того, для N. gorlenkoana EO мяты перечной и фунгицид Nativo 75WG также были наиболее эффективными, полностью подавляя рост мицелия при минимальных концентрациях. Компонент эвгенол был эффективен как для N. gorlenkoana, так и для N. philosophiae-doctoris.
P. iranianum является патогеном, вызывающим усыхание ветвей и побегов оливы, и до сих пор он был обнаружен только в Хорватии [14]. Было проведено единственное исследование по возможной борьбе с этим патогеном. Idbella et al. [79] изучали потенциальное применение биоугля для борьбы с этим патогеном на виноградной лозе, и результаты свидетельствуют о том, что патоген присутствовал исключительно в необработанной почве. В нашем исследовании EOs базилика священного, китайской корицы, душицы и тимьяна, а также компоненты Е-коричный альдегид, эвгенол и карвакрол, и фунгицид Cabrio TOP доказали свою высокую эффективность в ингибировании роста мицелия этого патогена.
S. fimicola является патогеном, вызывающим усыхание ветвей и побегов оливы, и был идентифицирован как причина заболевания оливы в Хорватии [3], а также поражает другие виды растений [80]. Доступны только более старые данные, начиная с 1979 года [81], относительно тестирования фунгицидов на этом виде. Автор обнаружил, что триадимефон, триадименол, фенаримол, нуаримол и имазалил оказывают токсическое действие на S. fimicola. Исследований с EOs не проводилось. В нашем исследовании EOs базилика священного, китайской корицы, душицы и тимьяна, наряду с компонентами Е-коричным альдегидом, карвакролом и эвгенолом, и оба фунгицида доказали свою высокую эффективность в ингибировании роста мицелия.
В целом, наилучший эффект в подавлении роста мицелия грибов, использованных в этом исследовании, был достигнут EOs корицы и душицы, наряду с их основными компонентами, Е-коричным альдегидом и карвакролом, которые полностью подавляли рост мицелия всех тестированных грибов. Напротив, наименее эффективные результаты наблюдались с EOs лимона и мяты перечной, а также с их компонентами лимоненом, ментолом и тимолом. Примечательно, что среди Dothideomycetes вид Do. iberica продемонстрировал самую высокую чувствительность ко всем примененным обработкам, в то время как среди Sordariomycetes это наблюдалось для вида N. gorlenkoana.
EOs снижают рост мицелия определенных фитопатогенных грибов [50]; нарушают клеточный метаболизм и нормальную функцию клеток [22]; приводят к морфологической дегенерации, включая коагуляцию цитоплазмы, дегенерацию гиф и утечку протоплазмы из гиф гриба [82]; вызывают митохондриальную дисфункцию, обусловленную активными формами кислорода [83]; снижают продукцию микотоксинов [84,85]; и уменьшают прорастание спор [86]. Благодаря своей гидрофобной природе EOs проходят через мембраны, вызывая нарушение липидного бислоя клеточной мембраны, что приводит к утечке клеточного содержимого и замедлению биосинтеза эргостерола (специфического стерола грибов) [87]. EOs вызывают гибель клеток, разрушая структуру клеточной мембраны [88]. Li et al. [51] изучали влияние карвакрола на гриб B. dothidea. Они пришли к выводу, что карвакрол влияет на морфологию и структуру мицелия гриба. После обработки карвакролом гифы гриба выглядели сморщенными и деформированными, наблюдались морщины, сухость и другие необратимые изменения, а также большее количество ветвлений и разрывов в мицелии. Кроме того, они заключили, что карвакрол вызывает гибель клеток в мицелии, нарушает ультраструктуру гиф патогена и значительно расширяет периплазматическое пространство между клеточной мембраной и клеточной стенкой. В клетках также наблюдался плазмолиз, при этом клеточное содержимое либо разрушалось, либо распределялось неравномерно. По сравнению с мицелием в контрольной группе, карвакрол значительно снижает общее содержание липидов и эргостерола в гифах B. dothidea и значительно увеличивает содержание МДА в патогене по сравнению с контрольной группой. Внеклеточная проводимость мицелия также увеличивалась при обработке карвакролом, как и внеклеточное содержание растворимых белков и сахаров. Это указывает на то, что карвакрол может воздействовать на проницаемость клеточной мембраны B. dothidea и может оказывать значительное влияние на митохондриальную активность B. dothidea.
В заключение, учитывая растущую распространенность патогенов, поражающих оливковые деревья, а также опасности и последствия, связанные с использованием пестицидов, разработка и применение альтернативных биологических методов защиты растений имеют решающее значение для устойчивого сельского хозяйства. Ожидается, что изменение климата повлияет на частоту возникновения и тяжесть инфекционных заболеваний оливок. Однако прогнозирование этих последствий затруднено из-за сложных взаимодействий между конкретными патогенами, генотипами оливы и факторами окружающей среды (такими как климат и агрономические практики). Чрезмерная влажность и повторяющиеся дожди благоприятствуют распространению и эпидемическому распространению грибковых заболеваний. Более мягкие зимы и более высокие ночные или общие температуры могут улучшить перезимовку определенных патогенов на оливковых деревьях или способствовать спорообразованию. Сильные дожди могут привести к насыщению почвы, увеличивая долгосрочные проблемы, такие как корневая гниль, вызываемая различными почвенными патогенами. Кроме того, может потребоваться корректировка сроков и дозировок химических или биологических продуктов, поскольку интенсивность и частота осадков, а также колебания температуры могут влиять на устойчивость и эффективность средств защиты растений, потенциально приводя к их деградации [1]. Более того, разработка новых стратегий защиты растений необходима в свете усилий ЕС по переходу от традиционных систем производства к экологически безопасному сельскому хозяйству [89].
EOs предлагают перспективную альтернативу химическим средствам защиты растений. Однако при тестировании их эффективности важно проводить измерения в течение длительного периода, так как большинство исследований оценивали их эффекты только через 48 часов. Это исследование свидетельствует о том, что воздействие EOs со временем ослабевает. Необходимы дальнейшие исследования для изучения их влияния на патогены и растения, а также для определения оптимальной дозировки, которая эффективна против патогенов, не нанося вреда растению или окружающей среде.
5. Выводы
Растущая распространенность патогенов оливковых деревьев в сочетании с рисками и неблагоприятными последствиями, связанными с использованием пестицидов, подчеркивают острую необходимость в разработке и внедрении альтернативных биологических стратегий защиты растений для содействия устойчивым методам ведения сельского хозяйства. EOs стали перспективной альтернативой синтетическим химикатам благодаря своим мощным антимикробным свойствам. Исследования показали, что синергетический эффект компонентов EOs в первую очередь ответственен за их противогрибковую активность. Химические профили EOs варьируются в зависимости от вида растения и подвержены влиянию многочисленных факторов. В этом исследовании EOs китайской корицы и душицы, наряду с их ключевыми компонентами, Е-коричным альдегидом и карвакролом, продемонстрировали наиболее эффективное ингибирование роста мицелия грибов, полностью подавляя рост всех тестированных грибов. Напротив, EOs лимона и мяты перечной, наряду с компонентами лимоненом, ментолом и тимолом, показали самые слабые противогрибковые эффекты. Однако для практического применения EOs необходимы дальнейшие исследования для оценки их долгосрочной эффективности, их воздействия на патогены и их потенциального влияния на сами обрабатываемые растения. Учитывая наблюдаемые различия в эффектах EOs на патогены, крайне важно проводить исследования, которые выяснят точные механизмы действия против патогенов. Кроме того, понимание взаимодействия между EOs и растениями-хозяевами необходимо для оптимизации их практического использования. Детальное изучение этих взаимодействий могло бы помочь адаптировать обработки к конкретным патогенам и растениям-хозяевам. Определение соответствующих дозировок, которые являются одновременно эффективными и экологически безопасными, также имеет решающее значение для более широкого применения.
В заключение, продолжающиеся исследования и инновации в стратегиях защиты растений необходимы для решения будущих сельскохозяйственных проблем при одновременном достижении целей устойчивого развития ЕС. Углубляя понимание и применение EOs, мы можем приблизиться к достижению эффективных, устойчивых и экологически безопасных решений для управления здоровьем растений.
Дополнительные материалы
Следующую вспомогательную информацию можно загрузить по адресу: https://www.mdpi.com/article/10.3390/agriculture15030340/s1
Таблица S1. Список использованных эфирных масел (EOs), латинские названия видов растений и компоненты EOs, присутствующие в концентрациях более 0,1%, а также торговые названия использованных фунгицидов, тип фунгицида и действующие вещества.
Таблица S2. Результаты однофакторного ANOVA (среднее ± стандартное отклонение, в мм) для роста мицелия Botryosphaeria dothidea под воздействием различных обработок. Средние значения с одинаковыми буквами в строке не имеют значительных различий согласно критерию Тьюки (p < 0,05).
Таблица S3. Ингибирующий эффект (%) эфирных масел, компонентов и фунгицидов на рост мицелия Botryosphaeria dothidea.
Таблица S4. Результаты однофакторного ANOVA (среднее ± стандартное отклонение, в мм) для роста мицелия Diplodia mutila под воздействием различных обработок. Средние значения с одинаковыми буквами в строке не имеют значительных различий согласно критерию Тьюки (p < 0,05).
Таблица S5. Ингибирующий эффект (%) эфирных масел, компонентов и фунгицидов на рост мицелия Diplodia mutila.
Таблица S6. Результаты однофакторного ANOVA (среднее ± стандартное отклонение, в мм) для роста мицелия Diplodia seriata под воздействием различных обработок. Средние значения с одинаковыми буквами в строке не имеют значительных различий согласно критерию Тьюки (p < 0,05).
Таблица S7. Ингибирующий эффект (%) эфирных масел, компонентов и фунгицидов на рост мицелия Diplodia seriata.
Таблица S8. Результаты однофакторного ANOVA (среднее ± стандартное отклонение, в мм) для роста мицелия Dothiorella iberica под воздействием различных обработок. Средние значения с одинаковыми буквами в строке не имеют значительных различий согласно критерию Тьюки (p < 0,05).
Таблица S9. Ингибирующий эффект (%) эфирных масел, компонентов и фунгицидов на рост мицелия Dothiorella iberica.
Таблица S10. Результаты однофакторного ANOVA (среднее ± стандартное отклонение, в мм) для роста мицелия Dothiorella sarmentorum под воздействием различных обработок. Средние значения с одинаковыми буквами в строке не имеют значительных различий согласно критерию Тьюки (p < 0,05).
Таблица S11. Ингибирующий эффект (%) эфирных масел, компонентов и фунгицидов на рост мицелия Dothiorella sarmentorum.
Таблица S12. Результаты однофакторного ANOVA (среднее ± стандартное отклонение, в мм) для роста мицелия Neofusicoccum parvum под воздействием различных обработок. Средние значения с одинаковыми буквами в строке не имеют значительных различий согласно критерию Тьюки (p < 0,05).
Таблица S13. Ингибирующий эффект (%) эфирных масел, компонентов и фунгицидов на рост мицелия Neofusicoccum parvum.
Таблица S14. Результаты однофакторного ANOVA (среднее ± стандартное отклонение, в мм) для роста мицелия Biscogniauxia mediterranea под воздействием различных обработок. Средние значения с одинаковыми буквами в строке не имеют значительных различий согласно критерию Тьюки (p < 0,05).
Таблица S15. Ингибирующий эффект (%) эфирных масел, компонентов и фунгицидов на рост мицелия Biscogniauxia mediterranea.
Таблица S16. Результаты однофакторного ANOVA (среднее ± стандартное отклонение, в мм) для роста мицелия Biscogniauxia nummularia под воздействием различных обработок. Средние значения с одинаковыми буквами в строке не имеют значительных различий согласно критерию Тьюки (p < 0,05).
Таблица S17. Ингибирующий эффект (%) эфирных масел, компонентов и фунгицидов на рост мицелия Biscogniauxia nummularia.
Таблица S18. Результаты однофакторного ANOVA (среднее ± стандартное отклонение, в мм) для роста мицелия Cytospora pruinosa под воздействием различных обработок. Средние значения с одинаковыми буквами в строке не имеют значительных различий согласно критерию Тьюки (p < 0,05).
Таблица S19. Ингибирующий эффект (%) эфирных масел, компонентов и фунгицидов на рост мицелия Cytospora pruinosa.
Таблица S20. Результаты однофакторного ANOVA (среднее ± стандартное отклонение, в мм) для роста мицелия Nigrospora gorlenkoana под воздействием различных обработок. Средние значения с одинаковыми буквами в строке не имеют значительных различий согласно критерию Тьюки (p < 0,05).
Таблица S21. Ингибирующий эффект (%) эфирных масел, компонентов и фунгицидов на рост мицелия Nigrospora gorlenkoana.
Таблица S22. Результаты однофакторного ANOVA (среднее ± стандартное отклонение, в мм) для роста мицелия Nigrospora osmanthi под воздействием различных обработок. Средние значения с одинаковыми буквами в строке не имеют значительных различий согласно критерию Тьюки (p < 0,05).
Таблица S23. Ингибирующий эффект (%) эфирных масел, компонентов и фунгицидов на рост мицелия Nigrospora osmanthi.
Таблица S24. Результаты однофакторного ANOVA (среднее ± стандартное отклонение, в мм) для роста мицелия Nigrospora philosophiae-doctoris под воздействием различных обработок. Средние значения с одинаковыми буквами в строке не имеют значительных различий согласно критерию Тьюки (p < 0,05).
Таблица S25. Ингибирующий эффект (%) эфирных масел, компонентов и фунгицидов на рост мицелия Nigrospora philosophiae-doctoris.
Таблица S26. Результаты однофакторного ANOVA (среднее ± стандартное отклонение, в мм) для роста мицелия Phaeoacremonium iranianum под воздействием различных обработок. Средние значения с одинаковыми буквами в строке не имеют значительных различий согласно критерию Тьюки (p < 0,05).
Таблица S27. Ингибирующий эффект (%) эфирных масел, компонентов и фунгицидов на рост мицелия Phaeoacremonium iranianum.
Таблица S28. Результаты однофакторного ANOVA (среднее ± стандартное отклонение, в мм) для роста мицелия Sordaria fimicola под воздействием различных обработок. Средние значения с одинаковыми буквами в строке не имеют значительных различий согласно критерию Тьюки (p < 0,05).
Таблица S29. Ингибирующий эффект (%) эфирных масел, компонентов и фунгицидов на рост мицелия Sordaria fimicola.
Таблица S30. Определенные значения MIC (минимальная ингибирующая концентрация) и MFC (минимальная фунгицидная концентрация) для обработок.
Ссылки
1. Landa, B.B. Pests and Diseases of the Olive Tree; EIP-AGRI Focus Group; European Commission: Brussels, Belgium, 2019; pp. 1–20. Available online: https://ec.europa.eu/eip/agriculture/sites/default/files/eip-agri_fg33_pests_and_diseases_olive_tree_starting_paper_2019_en.pdf (accessed on 15 October 2024).
2. FAO (Food and Agriculture Organization of United Nations). Crop and Livestock Products. Available online: https://www.fao.org/faostat/en/#data/QCL (accessed on 7 October 2024).
3. Petrović, E.; Godena, S.; Ćosić, J.; Vrandečić, K. Identification and Pathogenicity of Biscogniauxia and Sordaria Species Isolated from Olive Trees. Horticulturae 2024, 10, 243. [Google Scholar] [CrossRef]
4. Patejuk, K.; Baturo-Cieśniewska, A.; Pusz, W.; Kaczmarek-Pieńczewska, A. Biscogniauxia Charcoal Canker—A New Potential Threat for Mid-European Forests as an Effect of Climate Change. Forests 2022, 13, 89. [Google Scholar] [CrossRef]
5. Kim, G.-U.; Seo, K.-H.; Chen, D. Climate change over the Mediterranean and current destruction of marine ecosystem. Sci. Rep. 2019, 9, 18813. [Google Scholar] [CrossRef] [PubMed]
6. Úrbez-Torres, J.R.; Peduto, F.; Vossen, P.M.; Krueger, W.H.; Gubler, W.D. Olive Twig and Branch Dieback: Etiology, Incidence, and Distribution in California. Plant Dis. 2013, 97, 231–244. [Google Scholar] [CrossRef]
7. Petrović, E.; Vrandečić, K.; Belušić Vozila, A.; Ćosić, J.; Godena, S. Diversity and Pathogenicity of Botryosphaeriaceae Species Isolated from Olives in Istria, Croatia, and Evaluation of Varietal Resistance. Plants 2024, 13, 1813. [Google Scholar] [CrossRef]
8. Cvjetković, B. Mikoze i Pseudomikoze Voćnjaka Ivinove Loze; Zrinski d.d: Čakovec, Croatia, 2010. [Google Scholar]
9. Schena, L.; Mosca, S.; Cacciola, S.O.; Faedda, R.; Sanzani, S.M.; Agosteo, G.E.; Sergeeva, V.; Magnano di San Lio, G. Species of the Colletotrichum gloeosporioides and C. boninense complexes associated with olive anthracnose. Plant Pathol. 2013, 63, 437–446. [Google Scholar] [CrossRef]
10. Cvjetković, B.; Vončina, D. Paunovo oko [Spilocaea oleaginea (Castagne) Hughes] najučestalijaje bolest masline. Glas. Biljn. Zašt. 2012, 12, 336–340. [Google Scholar]
11. Kaliterna, J.; Miličević, T.; Benčić, D.; Mešić, A. First report of Verticillium wilt caused by Verticilium dahlie on olive trees in Croatia. Plant Dis. 2016, 100, 2526. [Google Scholar] [CrossRef]
12. Gharbi, Y.; Ennouri, K.; Bouazizi, E.; Cheffi, M.; Ali Triki, M. First report of charcoal disease caused by Biscogniauxia mediterranea on Olea europaea in Tunisia. J. Plant Pathol. 2020, 102, 961. [Google Scholar] [CrossRef]
13. Santilli, E.; Riolo, M.; La Spada, F.; Pane, A.; Cacciola, S.O. First Report of Root Rot Caused by Phytophthora bilorbang on Olea europaea in Italy. Plants 2020, 9, 826. [Google Scholar] [CrossRef]
14. Petrović, E.; Vrandečić, K.; Ćosić, J.; Kanižai Šarić, G.; Godena, S. First Report of Phaeoacremonium iranianum Causing Olive Twig and Branch Dieback. Plants 2022, 11, 3578. [Google Scholar] [CrossRef] [PubMed]
15. Brugneti, F.; Turco, S.; Drais, M.I.; Giubilei, I.; Mazzaglia, A. First report of the Fusarium arthrosporioides/avenaceum complex causing olive fruit rot in Italy. New Dis. Rep. 2023, 48, e12198. [Google Scholar] [CrossRef]
16. Petrović, E.; Vrandečić, K.; Ivić, D.; Ćosić, J.; Godena, S. First Report of Olive Branch Dieback in Croatia Caused by Cytospora pruinosa Défago. Microorganisms 2023, 11, 1679. [Google Scholar] [CrossRef] [PubMed]
17. Alzohairy, S.A.; Gillett, J.; Saito, S.; Naegele, R.N.; Xiao, C.L.; Miles, T.D. Fungicide Resistance Profiles of Botrytis cinerea Isolates from Michigan Vineyards and Development of a TaqMan Assay for Detection of Fenhexamid Resistance. Plant Dis. 2020, 105, 258–294. [Google Scholar] [CrossRef] [PubMed]
18. Petrović, E.; Vrandečić, K.; Ćosić, J.; Godena, S. Chemical Control of Olive Fungal Diseases: Strategies and Risks. Poljoprivreda 2024, 30, 44–53. [Google Scholar] [CrossRef]
19. Sarkhosh, A.; Schaffer, B.; Vargas, A.I.; Palmateer, A.J.; Lopez, P.; Soleymani, A. In Vitro Evaluation of Eight Plant Essential Oils for Controlling Colletotrichum, Botryosphaeria, Fusarium and Phytophthora Fruit Rots of Avocado, Mango and Papaya. Plant Prot. Sci. 2018, 54, 153–162. [Google Scholar] [CrossRef]
20. Rahman, S.M.A.; Yusef, H.; Halawi, J. Biological and chemical control of some tomato fungal diseases. Egypt. J. Bot. 2022, 62, 45–58. [Google Scholar] [CrossRef]
21. Burt, S.A.; Reinders, R.D. Antibacterial activity of selected plant essential oils against Escherichia coli O157:H7. Lett. Appl. Microbiol. 2003, 36, 162–167. [Google Scholar] [CrossRef]
22. Bakkali, F.; Averbeck, S.; Averbeck, D.; Idaomar, M. Biological effects of essential oils—A review. Food Chem. Toxicol. 2008, 46, 446–475. [Google Scholar] [CrossRef]
23. Tongnuanchan, P.; Benjakul, S. Essential oils: Extraction, bioactivities, and their uses for food preservation. J. Food Sci. 2014, 79, R1231–R1249. [Google Scholar] [CrossRef]
24. Božović, M.; Garzoli, S.; Sabatino, M.; Pepi, F.; Baldisserotto, A.; Andreotti, E.; Romagnoli, C.; Mai, A.; Manfredini, S.; Ragno, R. Essential oil extraction, chemical analysis and anti-Candida activity of Calamintha nepeta (L.) Savi subsp. glandulosa (Req.) Ball-New Approaches. Molecules 2017, 22, 203. [Google Scholar] [CrossRef] [PubMed]
25. Del Principe, S.; Mondo, L. Eterična Ulja; Trsat: Zagreb, Croatia, 2001; pp. 1–126. [Google Scholar]
26. Nazzaro, F.; Fratianni, F.; Coppola, R.; De Feo, V. Essential oils and antifungal activity. Pharmaceuticals 2017, 10, 86. [Google Scholar] [CrossRef] [PubMed]
27. Bowles, E.J. Eterična Ulja; Veble Commerce: Zagreb, Croatia, 2012. [Google Scholar]
28. Niu, C.; Gilbert, E.S. Colorimetric method for identifying plant essential oil components that affect biofilm formation and structure. Appl. Environ. Microbiol. 2004, 70, 6951–6956. [Google Scholar] [CrossRef] [PubMed]
29. Hyldgaard, M.; Mygind, T.; Meyer, R.L. Essential oils in food preservation: Mode of action, synergies and interactions with food matrix components. Front. Microbiol. 2012, 3, 12. [Google Scholar] [CrossRef]
30. Dorman, H.J.D.; Deans, S.G. Antimicrobial agents from plants: Antimicrobial activity of plant volatile oils. J. Appl. Microbiol. 2000, 88, 308–316. [Google Scholar] [CrossRef]
31. Burt, S. Essential oils: Their antibacterial properties and potential applications in foods—A review. Int. J. Food Microbiol. 2004, 94, 223–253. [Google Scholar] [CrossRef]
32. Iacobelis, N.S.; Lo Cantore, P.; Capasso, F.; Senatore, F. Antibacterial Activity of Cuminum cyminum L. and Carum carvi L. essential oils. J. Agric. Food Chem. 2005, 53, 57–61. [Google Scholar] [CrossRef]
33. Ćosić, J.; Vrandečić, K.; Jurković, D. The effect of essential oils on the development of phytopathogenic fungi. In Biological Controls for Preventing Food Deterioration—Strategies for Pre- and Postharvest Management; Sharma, N., Ed.; John Wiley & Sons: Hoboken, NJ, USA, 2014; pp. 273–292. [Google Scholar]
34. Karimi, K.; Arzanlou, M.; Pertot, I. Antifungal activity of the dill (Anethum graveolens L.) seed essential oil against strawberry anthracnose under in vitro and in vivo conditions. Arch. Phytopathol. Plant Prot. 2016, 49, 554–566. [Google Scholar] [CrossRef]
35. Petrović, E.; Vrandečić, K.; Ćosić, J.; Đermić, E.; Godena, S. First Report of Nigrospora Species Causing Leaf Spot on Olive (Olea europaea L.). Horticulturae 2023, 9, 1067. [Google Scholar] [CrossRef]
36. Edris, A.E.; Farrag, E.S. Antifungal activity of peppermint and sweet basil essential oils and their major aroma constituents on some plant pathogenic fungi from the vapor phase. Food/Nahrung 2003, 47, 117–121. [Google Scholar] [CrossRef]
37. Palfi, M. Antifungalno Djelovanje Eteričnih Ulja i Njihovih Komponenti na Fitopatogene Gljivice u In Vitro Uvjetima. Ph.D. Thesis, Josip Juraj Strossmayer University of Osijek, Faculty of Agrobiotechnical Sciences, Osijek, Croatia, 2017. [Google Scholar]
38. Wu, J.; Kang, S.; Luo, L.; Shi, Q.; Ma, J.; Yin, J.; Song, B.; Hu, D.; Yang, S. Synthesis and antifungal activities of novel nicotinamide derivatives containing 1, 3, 4-oxadiazole. Chem. Cen. J. 2013, 7, 64. [Google Scholar] [CrossRef] [PubMed]
39. Markakis, E.A.; Roditakis, E.N.; Kalantzakis, G.S.; Chatzaki, A.; Soultatos, S.K.; Stavrakaki, M.; Soultatos, S.K.; Stavrakaki, M.; Tavlaki, G.I.; Koubouris, G.C.; et al. Characterization of Fungi Associated with Olive Fruit Rot and Olive Oil Degradation in Crete, Southern Greece. Plant Dis. 2021, 105, 3623–3635. [Google Scholar] [CrossRef] [PubMed]
40. Lazzizera, C.; Frisullo, S.; Alves, A.; Phillips, A.J.L. Morphology, phylogeny and pathogenicity of Botryosphaeria and Neofusicoccum species associated with drupe rot of olives in southern Italy. Plant Pathol. 2008, 57, 948–956. [Google Scholar] [CrossRef]
41. Latinović, J.; Mazzaglia, A.; Latinović, N.; Ivanović, M.; Gleason, M.L. Resistance of olive cultivars to Botryosphaeria dothidea, causal agent of olive fruit rot in Montenegro. Crop Prot. 2013, 48, 35–40. [Google Scholar] [CrossRef]
42. Moral, J.; Agustí-Brisach, C.; Pérez-Rodríguez, M.; Xaviér, C.; Carmen-Raya, M.; Rhouma, A.; Trapero, A. Identification of fungal species associated with branch dieback of olive and resistance of table cultivars to Neofusicoccum mediterraneum and Botryosphaeria dothidea. Plant Dis. 2017, 101, 306–316. [Google Scholar] [CrossRef]
43. Chattaoui, M.; Rhouma, A.; Krid, S.; Ali Triki, M.; Moral, J.; Msallem, M.; Trapero, A. First Report of Fruit Rot of Olives Caused by Botryosphaeria dothidea in Tunisia. Plant Dis. 2011, 95, 770. [Google Scholar] [CrossRef]
44. Avan, M. Identification and Characterization of Leaf Blight Caused by Botryosphaeria dothidea (Moug. Ex Fr.) Ces. & De Not. on Olive Tree (Olea europaea) in Adıyaman, Turkiye. Appl. Fruit Sci. 2024, 66, 1487–1492. [Google Scholar] [CrossRef]
45. Hernández-Rodríguez, L.; Mondino-Hintz, P.; Alaniz-Ferro, S. Diversity of Botryosphaeriaceae species causing stem canker and fruit rot in olive trees in Uruguay. J. Phytopathol. 2022, 170, 264–277. [Google Scholar] [CrossRef]
46. Moral, J.; Luque, F.; Trapero, A. First report of Diplodia seriata, the anamorph of “Botryosphaeria” obtusa, causing fruit rot of olive in Spain. Plant Dis. 2008, 92, 311. [Google Scholar] [CrossRef]
47. Linaldeddu, B.T.; Rossetto, G.; Maddau, L.; Vatrano, T.; Bregant, C. Diversity and Pathogenicity of Botryosphaeriaceae and Phytophthora Species Associated with Emerging Olive Diseases in Italy. Agriculture 2023, 13, 1575. [Google Scholar] [CrossRef]
48. Carlucci, A.; Raimondo, M.L.; Cibelli, F.; Phillips, A.J.L.; Lops, F. Pleurostomophora richardsiae, Neofusicoccum parvum and Phaeoacremonium aleophilum associated with a decline of olives in southern Italy. Phytopathol. Mediterr. 2013, 52, 517–527. [Google Scholar] [CrossRef]
49. van Dyk, M.; Spies, C.F.J.; Mostert, L.; van der Rijst, M.; du Plessis, I.L.; Moyo, P.; van Jaarsveld, W.J.; Halleen, F. Pathogenicity Testing of Fungal Isolates Associated with Olive Trunk Diseases in South Africa. Plant Dis. 2021, 105, 4060–4073. [Google Scholar] [CrossRef] [PubMed]
50. Ammad, F.; Moumen, O.; Gasem, A.; Othmane, S.; Hisashi, K.-N.; Zebib, B.; Merah, O. The potency of lemon (Citrus limon L.) essential oil to control some fungal diseases of grapevine wood. Comptes Rendus Biol. 2018, 341, 97–101. [Google Scholar] [CrossRef] [PubMed]
51. Li, J.; Fu, S.; Fan, G.; Li, D.; Yang, S.; Peng, L.; Pan, S. Active compound identification by screening 33 essential oil monomers against Botryosphaeria dothidea from postharvest kiwifruit and its potential action mode. Pestic. Biochem. Physiol. 2021, 179, 104957. [Google Scholar] [CrossRef] [PubMed]
52. Zhang, Z.; Xie, Y.; Hu, X.; Shi, H.; Wei, M.; Lin, Z. Antifungal Activity of Monoterpenes against Botryosphaeria dothidea. Nat. Prod. Commun. 2018, 13, 1721–1724. [Google Scholar] [CrossRef]
53. Wang, D.; Wang, G.; Wang, J.; Zhai, H.; Xue, X. Inhibitory effect and underlying mechanism of cinnamon and clove essential oils on Botryosphaeria dothidea and Colletotrichum gloeosporioides causing rots in postharvest bagging-free apple fruits. Front. Microbiol. 2023, 14, 1109028. [Google Scholar] [CrossRef]
54. Dai, D.J.; Wang, H.D.; Wang, Y.P.; Zhang, C.Q. Management of Chinese hickory (Carya cathayensis) trunk canker through effective fungicide application programs and baseline sensitivity of Botryosphaeria dothidea to trifloxystrobin. Australas. Plant Pathol. 2017, 46, 75–82. [Google Scholar] [CrossRef]
55. Fan, K.; Fu, L.; Liu, H.; Qu, J.; Zhang, G.; Zhang, S.; Qiao, K. Reduced Sensitivity to Tebuconazole in Botryosphaeria dothidea Isolates Collected from Major Apple Production Areas of China. Plant Dis. 2022, 106, 2817–2822. [Google Scholar] [CrossRef]
56. Latorre, B.A.; Torres, R.; Silva, T.; Elfar, K. Evaluation of the use of wound-protectant fungicides and biological control agents against stem canker (Neofusicoccum parvum) of blueberry. Cienc. Investig. Agrar. 2013, 40, 547–557. [Google Scholar] [CrossRef]
57. Twizeyimana, M.; McDonald, V.; Mayorquin, J.S.; Wang, D.H.; Na, F.; Akgül, D.S.; Eskalen, A. Effect of Fungicide Application on the Management of Avocado Branch Canker (Formerly Dothiorella Canker) in California. Plant Dis. 2013, 97, 897–902. [Google Scholar] [CrossRef]
58. Štůsková, K.; Mondello, V.; Hakalová, E.; Tekielska, D.; Fontaine, F.; Eichmeier, A. Phenolic compounds inhibit viability and infectivity of the grapevine pathogens Diplodia seriata, Eutypa lata, Fomitiporia mediterranea, and Neofusicoccum parvum. Phytopathol. Mediterr. 2023, 62, 307–319. [Google Scholar] [CrossRef]
59. Tao, D.; Li, Y.; Lu, D.; Luo, Y.; Yu, S.; Ye, S. The essential oil components of Cinnamomum cassia: An analysis under different thinning models of plantation Pinus massoniana. J. For. Res. 2015, 27, 707–717. [Google Scholar] [CrossRef]
60. Le, V.D.; Tran, V.T.; Dang, V.S.; Nguyen, D.T.; Dang, C.H.; Nguyen, T.D. Physicochemical characterizations, antimicrobial activity and non-isothermal decomposition kinetics of Cinnamomum cassia essential oils. J. Essent. Oil Res. 2019, 32, 158–168. [Google Scholar] [CrossRef]
61. Paw, M.; Begm, T.; Gogoi, R.; Pandey, S.K.; Lal, M. Chemical composition of Citrus limon L. burmf peel essential oil from north east India. J. Essent. Oil Bear. Plants 2020, 23, 337–344. [Google Scholar] [CrossRef]
62. Soković, M.D.; Vukojević, J.; Marin, P.D.; Brkić, D.D.; Vajs, V.; Van Griensven, L.J.L.D. Chemical composition of essential oils of Thymus and Mentha species and their antifungal activities. Molecules 2009, 14, 238–249. [Google Scholar] [CrossRef]
63. Moghaddam, M.; Pourbaige, M.; Tabar, H.K.; Farhadi, N.; Hosseini, S.M.A. Composition and antifungal activity of peppermint (Mentha piperita) essential oil from Iran. J. Essent. Oil Bear. Plants 2013, 16, 506–512. [Google Scholar] [CrossRef]
64. Awasthi, P.K.; Dixit, S.C. Chemical compositions of Ocimum sanctum Shyama and Ocimum sanctum Rama oils from the plains of northern India. J. Essent. Oil Bear. Plants 2007, 10, 292–296. [Google Scholar] [CrossRef]
65. Kazem, M. Phytochemical composition of Thymus vulgaris L. essential oil. J. Essent. Oil Bear. Plants 2015, 18, 751–753. [Google Scholar] [CrossRef]
66. Laghmouchi, Y.; Belmehdi, O.; Senhaji, N.S.; Abrini, J. Chemical composition and antibacterial activity of Origanum compactum Benth. essential oils from different areas at northern Morocco. S. Afr. J. Bot. 2018, 115, 120–125. [Google Scholar] [CrossRef]
67. Jeldi, L.; Taarabt, K.O.; Mazri, M.A.; Ouahmane, L.; Alfeddy, M.N. Chemical composition, antifungal and antioxidant activities of wild and cultivated Origanum compactum essential oils from the municipality of Chaoun, Morocco. S. Afr. J. Bot. 2022, 147, 852–858. [Google Scholar] [CrossRef]
68. Karami, J.; Kavosi, M.R.; Babanezhad, M.; Kiapasha, K. Integrated management of the charcoal disease by silviculture, chemical and biological methods in forest parks. J. Sustain. For. 2017, 37, 429–444. [Google Scholar] [CrossRef]
69. Rodrigo, S.; Santamaria, O.; Halecker, S.; Lledó, S.; Stadler, M. Antagonism between Byssochlamys spectabilis (anamorph Paecilomyces variotii) and plant pathogens: Involvement of the bioactive compounds produced by the endophyte. Ann. Appl. Biol. 2017, 171, 464–476. [Google Scholar] [CrossRef]
70. Coelho, V.; Nunes, L.; Gouveia, E. Short and long term efficacy and prevalence of Cryphonectria parasitica hypovirulent strains released as biocontrol agents of chestnut blight. Eur. J. Plant Pathol. 2021, 159, 769–781. [Google Scholar] [CrossRef]
71. Costa, D.; Tavares, R.M.; Baptista, P.; Lino-Neto, T. Cork Oak Endophytic Fungi as Potential Biocontrol agents Against Biscogniauxia mediterranea and Diplodia corticola. J. Fungi 2020, 6, 287. [Google Scholar] [CrossRef]
72. Yangui, I.; Boutiti, M.Z.; Boussaid, M.; Messaoud, C. Essential Oils of Myrtaceae Species Growing Wild in Tunisia: Chemical Variability and Antifungal Activity Against Biscogniauxia mediterranea, the Causative Agent of Charcoal Canker. Chem. Biodivers. 2017, 14, e1700058. [Google Scholar] [CrossRef]
73. Adams, G.C.; Roux, J.; Wingfield, M.J. Cytospora species (Ascomycota, Diaporthales, Valsaceae): Introduced and native pathogens of trees in South Africa. Australas. Plant Pathol. 2006, 35, 521–548. [Google Scholar] [CrossRef]
74. Liu, Y.J.; Hu, F.; Chen, L.S.; Xu, S.W. First report of Nigrospora sphaerica causing leaf blight on oil tea (Camellia oleifera) in China. Plant Dis. 2020, 104, 3252. [Google Scholar] [CrossRef]
75. Ismail, S.I.; Razak, N.F.A. First report of Nigrospora sphaerica causing leaf spot on watermelon (Citrullus lanatus L.) in Malaysia. Plant Dis. 2020, 105, 488. [Google Scholar] [CrossRef]
76. Raza, M.; Zhang, Z.-F.; Hyde, K.D.; Diao, Y.-Z.; Cai, L. Culturable plant pathogenic fungi associated with sugarcane in southern China. Fungal Divers. 2019, 99, 1–104. [Google Scholar] [CrossRef]
77. Li, W.J.; Hu, M.; Xue, Y.; Li, Z.; Zhang, Y.; Zheng, D.; Lu, G.; Wang, J.; Zhou, J. Five fungal pathogens are responsible for bayberry twig blight and fungicides were screened for disease control. Microorganisms 2020, 8, 689. [Google Scholar] [CrossRef]
78. Rahman, A.U.; Ashraf, M.; Choudary, M.I.; Rehman, H.U.; Kazmi, M.H. Antifungal aryltetralin lignans from leaves of Podophyllum hexandrum. Phytochemistry 1995, 40, 427–431. [Google Scholar] [CrossRef]
79. Idbella, M.; Baronti, S.; Vaccari, F.P.; Abd-ElGawad, A.M.; Bonanomi, G. Long-Term Application of Biochar Mitigates Negative Plant–Soil Feedback by Shaping Arbuscular Mycorrhizal Fungi and Fungal Pathogens. Microorganisms 2024, 12, 810. [Google Scholar] [CrossRef] [PubMed]
80. Ivanová, H. Sordaria fimicola (Ascomycota, Sordariales) on Acer palmatum. Folia Oecol. 2015, 42, 67–71. [Google Scholar]
81. Buchenauer, H. Comparative studies on the antifungal activity of triadimefon, triadimenol, fenarimol, nuarimol, imazalil and fluotrimazole in vitro. J. Plant Dis. Prot. 1979, 86, 341–354. [Google Scholar]
82. Adebayo, O.; Dang, T.; Bėlanger, A.; Khanizadeh, S. Antifungal studies of sellected essential oils and commercial formulation againist Botrytis cinerea. J. Food Res. 2013, 2, 217–226. [Google Scholar] [CrossRef]
83. Tian, J.; Ban, X.; Zeng, H.; He, J.; Chen, Y.; Wang, Y. The mechanism of antifungal action of essential oil from dill (Anethum graveolens L.) on Aspergillus flavus. PLoS ONE 2012, 7, e30147. [Google Scholar] [CrossRef]
84. El Khoury, R.; Atoui, A.; Verheecke, C.; Maroun, R.; El Khoury, A.; Mathieu, F. Essential oils modulate gene expression and ochratoxin A production in Aspergillus carbonarius. Toxins 2016, 8, 242. [Google Scholar] [CrossRef]
85. Rodrigues, M.P.; Astoreca, A.L.; de Oliviera, A.A.; Salvato, L.A.; Biscoto, G.L.; Keller, L.A.M.; Rosa, C.A.d.R.; Cavaglieri, L.R.; de Azevedo, M.I.; Keller, K.M. In vitro activity of Neem (Azadirachta indica) oil on growth and Ochratoxin A production by Aspergillus carbonarius isolates. Toxins 2019, 11, 579. [Google Scholar] [CrossRef]
86. Vitoratos, A.; Bilalis, D.; Karkanis, A.; Efthimiadou, A. Antifungal activity of plant essential oils against Botrytis cinerea, Penicillium italicum and Penicillium digitatum. Not. Bot. Hortic. Agrobot. Cluj-Napoca 2013, 41, 86–92. [Google Scholar] [CrossRef]
87. Kedia, A.; Jha, D.K.; Dubey, N.K. Plant essential oils as natural fungicides against stored product fungi. the battle against microbial pathogens: Basic science. Technol. Adv. Educ. Programs 2015, 2, 208–214. [Google Scholar]
88. Harris, R. Progress with superficial mycoses using essential oils. Int. J. Aromather. 2002, 12, 83–91. [Google Scholar] [CrossRef]
89. Bažok, R. Je li održiva uporaba pesticida doista održiva? Glas. Biljn. Zaštite 2020, 20, 384–389. [Google Scholar]
Petrović E, Vrandečić K, Ćosić J, Siber T, Godena S. Antifungal Efficacy of Essential Oils and Their Predominant Components Against Olive Fungal Pathogens. Agriculture. 2025; 15(3):340. https://doi.org/10.3390/agriculture15030340
Перевод статьи «Antifungal Efficacy of Essential Oils and Their Predominant Components Against Olive Fungal Pathogens» авторов Petrović E, Vrandečić K, Ćosić J, Siber T, Godena S., оригинал доступен по ссылке. Лицензия: CC BY. Изменения: переведено на русский язык
Фото: freepik

Комментарии (0)